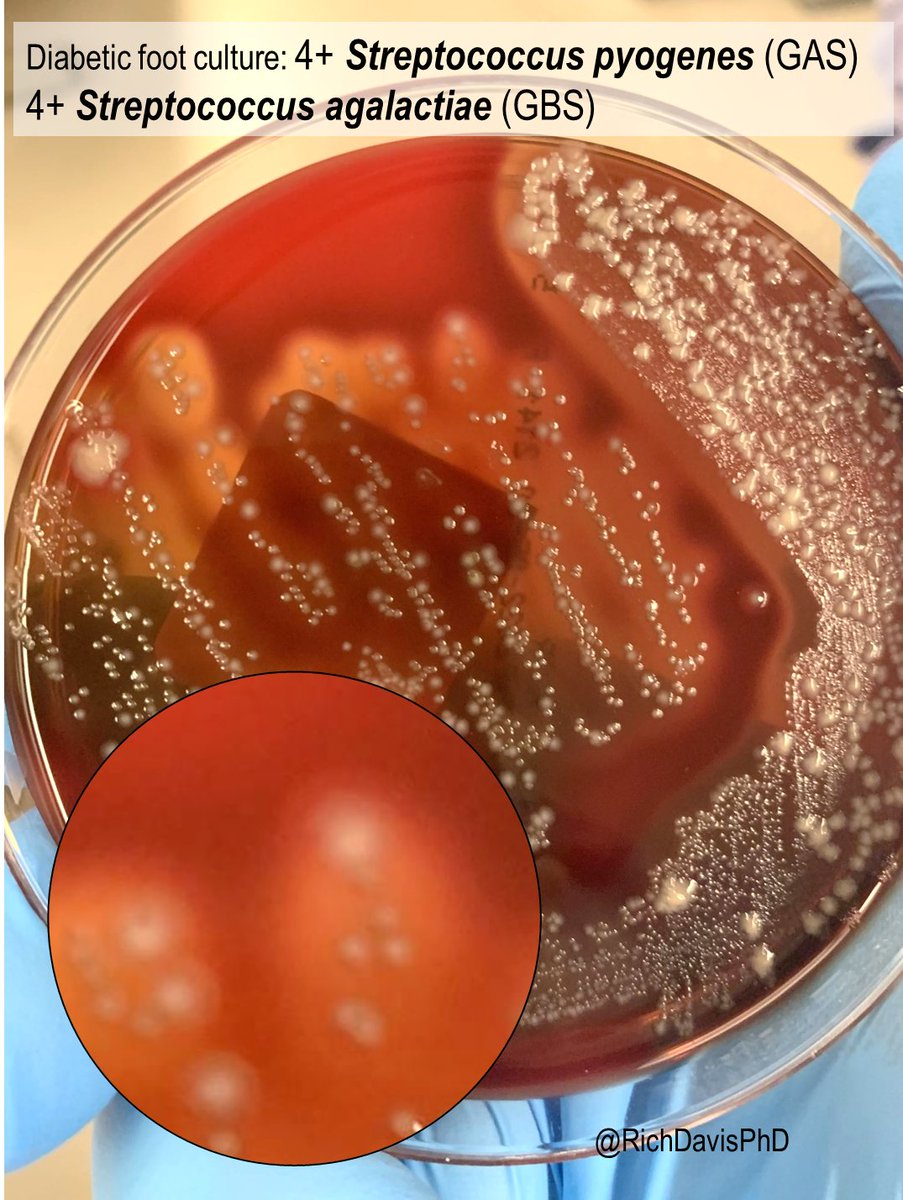

Стрептококк На Коже Фото
Торт Молочная Девочка Классический Рецепт С Фото
Букет Ромашек Из Шаров Фото
Голы Мужчины Фото
Фото Женщин Одиноких Вконтакте
Лазерная Эпиляция Верхней Губы Отзывы Фото
Сайдинг С Коричневой Крышей Фото
Главный Герой Черно Белая Любовь Фото
Роман Кош Крымские Горы Фото
Нити Шея Фото
Выпускные Фотографии Реутовской Школы Номер Двадцать
Топленое Молоко Рецепт С Фото
Украденные Семейные Фото
Фото Маши Лебедевой Из Пацанок
Стрептококк На Коже Фото 113 фотографий